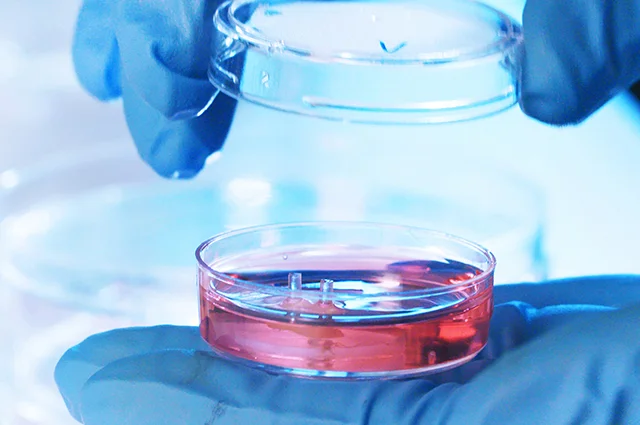

Treatments
The most advanced treatments & interventions to optimize recovery, healing, & health
Complex Spine, Nerve, & Pain Interventions:
- Neck and Back Pain-- Cervical, Thoracic, Lumbar, Sacral Spine Procedures & Minimally-Invasive Image-Guided Complex Spinal Interventional Procedures.
- Minimally-Invasive Interventions for Degenerative Disc Disease, Bulging Discs, Herniated Discs, Disc Protrusions, Disc Regeneration, Degenerative Facet Joint Arthritis, Arthrosis, Arthropathy, Facet Hypertrophy, Facet Joint Repair, Bone Spurs (Osteophytes), Ligament Laxity & Degeneration, & Scoliosis Spinal Deformity.
- Minimally-Invasive Interventions for CranioCervical Instability, Atlanto-Occipital and Atlanto-Axial Joint Instability using C0-C1, C1-2, Facet Injections, Alar & Transverse Ligament Injections, & Disc Injections.
- Minimally-Invasive Treatments for Failed Back Surgery, Non-Union Fractures, Pars Fracture Defects, Odontoid Dens Fractures, Spondylolysis, Spondylolisthesis, Spondylosis, & Regenerative Fracture Patching.
- Athroscopic Visualization & Endoscopic Spine Procedures of Nerve Roots, Pars Fracture Defects, Spondylosis, Spondylolysis, Facet Joint Arthrosis, Facet Hypertrophy, Disc Fissures, Disc Osteophyte Complexes, Disc Degeneration, Disc Herniations, Extrusions, Protrusions, Bulges, & Annular Ligament Fissures & Radial Tears.
- Spinal Epidural Injections, Facet Injections, & Medial Branch Nerve Blocks, Ablations, Transections, & Repairs.
- Intra-Discal Injections, Disc Sealant, Disc Regeneration, & Disc Patching of Annular & Radial Tears.
- Intra-Vertebral Injections and Minimally-Invasive Repair of Spine Fractures (Pars Defects & Vertebral Fractures), Non-Union Fractures, Avascular Necrosis, Odontoid Dens Fractures, Kyphoplasty, Vertebroplasty, & Regenerative Fracture Patching.
- Intra-Articular Injections and Minimally-Invasive Repair of Facet Injuries, Facet Arthritis, Facet Synovial Cysts, Spondylosis, Facet Hypertrophy, & Regenerative Joint Cartilage Patching.
- Minimally-Invasive Image-Guided Decompression & Release of Peripheral Nerve Entrapments including Cubital Tunnel, Ischial Tunnel, Tarsal Tunnel, & Carpal Tunnel Syndromes with Hydrodissection and Regenerative Agents.
- Sports Neurology & Image-Guided Trigger Point Injections, Regional Nerve Blocks, Decompressions, & Releases.
- Image-Guided Injections at Compressed Nerve Root Entrapment Sites & Herniated Discs (Epidural Steroid Injections).
- Minimally-Invasive Image-Guided Decompression & Release of Pinched, Entrapped, or Injured Nerve, Plexus, or Ganglion of Head, Spine, Neck, Back, Sacrum, Pelvis, and Peripheral Nerves.
- Cancer Pain & Complex Regional Pain Treatments of Head, Neck, Back, Spine, Shoulders, Ribs, Hips, Limbs, and Joints.
- Complex Regional Pain Syndrome (CRPS) Treatments and Autonomic Sympathetic Stellate Ganglion Block, Sphenopalatine Ganglion Block, Trigeminal Gasserian Ganglion Neuralgia, etc.
- Image-Guided Stem Cell Therapies with Platelet-Rich Fibrin (PRF) Patching to Enhance Tissue Integration & Healing with Protein Matrix & Activated Growth Factors.
- BioRegenerative Stem Cells, PRF, PRP, Peptides & Peptide Therapies.
- Therapies for Cognition, Concussion, Traumatic Brain Injury, Dementia, Neurodegeneration, Cervicogenic Headaches, Migraines, Nerve Injury, and Spinal Cord Injury Sequelae.
- Bone Marrow Stem Cell, Platelet-Rich/Leukocyte-Rich Plasma Injections and Prolotherapy for Joint Instability and Capsular Ligament Laxity.
- Minimally-Invasive Interventions for Spinal Stenosis, Neuroforaminal Stenosis, Radiculopathies, Thoracic Outlet Syndrome, Nerve Compression, Tunnel Syndromes, Brachial Plexus, Cervical Plexus, Nerve Pain, Nerve Entrapments, & Neuropathies.
- Peripheral Nerve Stimulators, Transcutaneous Electrical Nerve Stimulation (TENS), Neuromuscular Stimulation, Nerve Ablations, & Nerve Repair.
- Thoracic Outlet Syndrome Decompression & Brachial Plexus Release Interventions.
Interventional Orthopedic Surgery & Sports Medicine:
- Ultra-Minimally-Invasive Interventional Procedures and Microsurgeries.
- Regenerative Patching of Cartilage Damage, Cartilage Delamination, Chondral Fissures, Fractures, Defects, & Joint Damage.
- Image-Guided Plasma PRP, PRF, & Bone Marrow Stem Cell Injections & Minimally-Invasive Connective Tissue Repair for Protein Matrix Scaffolding and Release of Growth Factors at Injury Sites.
- Minimally-Invasive Patching & Repair of Tendon, Ligament, Muscle, Joint, Cartilage, Bone, and Tissue Injuries, Contusions, Avulsions, & Tears.
- Treatments for Tendinopathy, Tendonitis, Tendinosis, Tenosynovitis, Tendon Strains, Tears, & Avulsions.
- Treatments for Ligament Sprains, Tears, Avulsions, Instabilities, Subluxations, & Dislocations.
- Minimally-Invasive Image-Guided Nerve Entrapment Release of Impingments & Nerve Tunnel Syndromes.
- Minimally-Invasive Spine & Nerve Endoscopic Spine Surgery Procedures.
- Minimally-Invasive Nano Needle Joint Arthroscopy.
- Minimally-Invasive Image-Guided Injections of SI Joints, Hips, Knees, Ankles, Feet, Toes, Shoulders, Elbows, Wrists, Hands, and Finger Joints.
- Regenerative Patching of Joint Cartilage, Meniscus, & Labrum Tears.
- Ankle Injections of Tibio-Talar, Subtalar, Chopart, Lisfranc, Tibio-Fibular, TMT & MTP Joints & Ligamentous Ankle Sprains, Instabilities, & Tears.
- Minimally-Invasive Repair of Rotator Cuff Tears, Labrum Tears, Meniscus Tears, TFCC Tears, Tendon Tears, Plantar Fasciitis, etc.
- Intraosseous Injections in Non-Union Bone Fractures, Subchondral Injuries, Osteoporosis, Osteonecrosis, Avascular Necrosis, Scaphoid Fractures, Osgood-Schlatter, Legg-Calve-Perthes, and other Bone Injuries and Defects.
- Rib Injections of Costochondral, Costotransverse, and Costovertebral Joint & Ligament Structures and Intercostal and Subcostal Nerves.
- High-Resolution 3D Image-Guidance for Advanced Diagnostics & Interventional Spine & Orthopedic Procedures.
- Peptides & Biologics for Injury Repair.
- Ground-Breaking Osteoarthritis Treatments & Viscosupplementation Injections for Knee, Hip, Ankle, etc.
- New Joint Preservation Solutions to Avoid Surgery & Joint Replacement.
- Autologous Mesenchymal Stem Cell Harvesting from Bone Marrow Aspirate Concentrate or Stromal Vascular Fraction of Adipose Tissue.
- Focused & Radial Extracorporeal Shockwave Therapy (ESWT) for Spine, Joint, Muscle, Tendon, Ligament, & Neuropathic Injuries.
- Treatments for Traumatic & Degenerative Orthopedic Injuries.
- Sports Physicals, Concussion Protocols, Advanced Brain Imaging, Focused Cerebrovascular & Cardiovascular Assessments.
- Customized IV Infusions of Nutrients/Fluids/Electrolytes and Recovery Therapies.
- High Altitude Medicine, Wilderness Medicine, Search & Rescue, Expedition Medicine, Travel Medicine, & Telemedicine with Field Lab Testing and Image-Guided Diagnostics & Interventions.
Regenerative Treatments, Image-Guided Interventions, & Tissue Engineering Procedures:
- Stem Cell Therapies.
- Stem Cell Therapies for Orthopedic & Neurological Injuries & Conditions.
- PRF, PRP, A2M, Orthobiologics, & Plasma-Derived Treatments.
- Minimally-Invasive Image-Guided Stem Cell Patching at Injury Sites with Protein Matrix Hydrogels.
- Tissue Engineering Strategies with Regenerative Scaffolding Matrix & Stem Cell Hydrogel Patches.
- Peptides & Biologics for Enhanced Tissue Repair.
- Mesenchymal Stem Cell Optimization, Bone Marrow Aspirate Biopsy, & Bone Marrow Stimulation.
- Complex Image-Guided Minimally-Invasive Regenerative Procedures for Spine, Joints, Ligaments, Tendons, Cartilage, Bones, Muscles, Nerves, Vessels, & Organs.
Complex Medical Care, Urgent Care, Advanced Imaging, & Specialty Lab
Tests:
- Urgent Care, Suturing, & Wound Care.
- Wilderness Medicine, Acute Critical Care, High Altitude Medicine, & Telemedicine.
- Specialized IV Infusions & Fluid/Electrolyte/Vitamin/Nutrition Recovery Therapies.
- Difficult Venous Access, Cardiovascular & Cerebrovascular Imaging, Vascular Blood Flow Analysis, & Advanced Vascular Line Insertions.
- High-Resolution MSK Ultrasound Imaging for Advanced Diagnostic Imaging & Interventional Procedures of Bones, Cartilage, Joints, Discs, Labrum, Tendons, Ligaments, Muscles, & Nerves.
- Diagnostic Ultrasound Imaging & 3D CT Imaging.
- HIFU & LIFU Applications in Parkinson's, Alzheimer's, & Blood-Brain Barrier Delivery.
- Treatment of Cancer Complications and Adjuvant Cancer Therapies.
- Therapeutics for Rare & Neglected Diseases.
- Specialized Prescriptions, Labs, & Imaging Studies.
Cellular Repair & Function, Cognition, Concussion, Neuroprotection, Regenerative Cosmetics, Health & Wellness:
- Scientifically-Supported Therapeutic Agents for Improved Cell Recovery, Cell Function, Tissue Repair, Cognition & Concussion Therapies.
- Therapeutic Modulators of Signaling Pathways in Aging: Sirtuin, mTOR, AMPK, WNT, HDAC, GH, Telomerase, etc.
- Peptides, Biologics, & Infusions for Enhanced Recovery & Function.
- Medical Therapies for Concussion, Dementia, Neurodegeneration, Stroke, Traumatic Brain & Spinal Cord Injuries, Neuroprotection & Cognitive Enhancement.
- Cerebrovascular Imaging, TransCranial Doppler, and Opening of Blood-Brain Barrier with Ultrasound Imaging and MicroBubble Resonance for Delivery of Medications & Regenerative Agents.
- Cardiac & Carotid Ultrasound Imaging for Cardiovascular Disease Assessment and Arterio-Venous Blood Flow Doppler Ultrasound Imaging.
- Scar Tissue Reduction, Arthrofibrosis, Adhesions and Keloid Treatments.
- Specialized IV Infusion Therapies of Vitamins, Nutrients, Electrolytes, Antioxidants, Immune Enhancers, Anti-Inflammatory Agents, L-Carnitine, Vitamin C, Glutathione, Alpha-Lipoic Acid (ALA), Thiamine, Amino Acids, Peptides, NAD+, Ketamine Therapy, & Regenerative Agents.
- Prevention & Treatment of Cancer Complications.
- Injections for Hair Regrowth & Restoration of Hair Loss.
- Regenerative Cosmetics, Body Contouring, Hormone Optimization, & Weight Loss Interventions.
- Athletic Health, Immune Health, Nutritional Health, Integrative Functional Medicine.
- Regenerative Medicine Interventions and Related Research Studies.
And much more!
-----
ASOI © 2021 All Rights Reserved